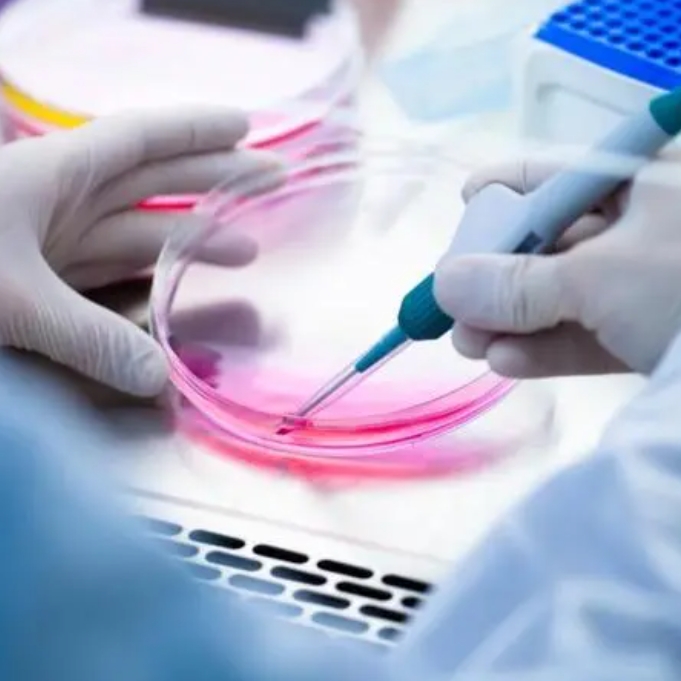

细胞培养技术,生物学中的一项基础而又强大的实践方法,涉及从动植物或动物中提取细胞并在人工控制的环境里促使其生长。这些细胞提取途径多样,既可通过酶解离、物理手段直接自组织而来,也能取自既有的细胞系或株系。细胞培养技术不仅是生物工程学的核心,尤其在生物克隆技术中扮演关键角色,它是细胞大规模扩增殖的基石,无论是微生物还是复杂的细胞培养,皆能从单一细胞繁衍生成大量的单一或少分化的多细胞群落,体现了克隆的本质。
直观细胞结构与生命活动观察:为细胞学、遗传学、免疫学、实验医学及肿瘤学等多个学科提供直接的研究窗口,洞悉察细胞形态及生命活动。
动态捕捉与记录:便于直接观察细胞形态变化,利于拍照记录,为研究进程与比较提供实证。
广泛适用性:涵盖广泛细胞种类,从低等到高等生物,胚胎至成熟,正常组织到肿瘤细胞,满足多样需求。
多技术兼容:与相差显微镜、电子显微镜、免疫化学染色、同位素标记等多种技术结合,全面分析细胞状态。
分子生物学与基因工程基础:作为分子生物学与基因工程研究的核心工具与基础,推动科学进步。
物理与化学研究便利:便于物理、化学性质的研究介入,探究细胞响应与影响。
经济高效:提供大量一致的实验对象,节约资源,成本效益高,便于对比研究。
生物制品与基因工程原料:为单克隆抗体制造、基因工程等生物制品提供原材料,推动生物科技发展。
综上所述,细胞培养技术不仅为生命科学的诸多领域提供了基本研究平台,还为生物技术产业的发展贡献了关键的原料与技术支撑,其在现代生物科学中占据着不可替代的地位。